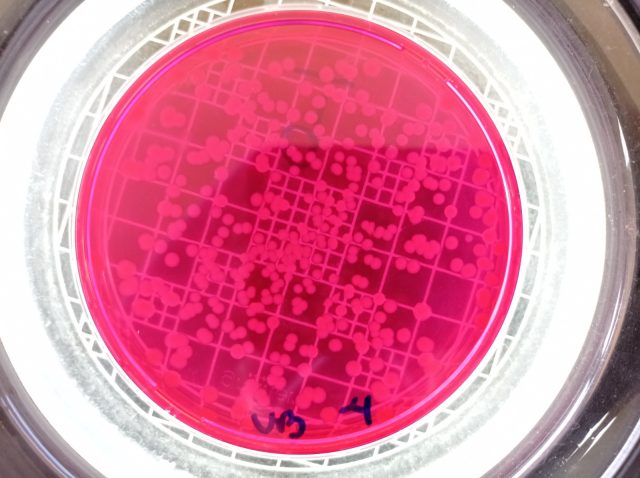
Biofármaco

A Embrapa Suínos e Aves (SC) vem avançando no desenvolvimento de um protótipo de biofármaco à base de bacteriófagos. O objetivo é controlar salmonelas avícolas que causam contaminação da carne de frango e salmonelose em humanos. Bacteriófagos são vírus amplamente distribuídos na natureza e que atuam especificamente sobre bactérias. Essa ação bactericida representa uma alternativa ao uso de antibióticos.
-
Levedura é opção econômica e sustentável para a alimentação de peixes
De acordo com as informações da Embrapa, os pesquisadores isolaram e estudaram três desses vírus, que compõem a coleção de microrganismos da unidade, e reúnem as características desejadas para controle de determinados sorotipos de salmonela.
Além disso, a pesquisa atende a uma das prioridades da produção animal atualmente, que é a manutenção de rebanhos e plantéis livres de patógenos que causam doenças transmitidas por alimentos e assim garantir a inocuidade dos produtos.
A resistência a antimicrobianos é um dos temas mais relevantes nesse contexto, e tem direcionado políticas públicas pela interface que tem com o conceito de saúde única, pela inter-relação com saúde humana, animal e meio ambiente. Contudo, a disseminação de microrganismos multirresistentes aos antimicrobianos disponíveis e a falta de desenvolvimento de novas classes de antimicrobianos têm sido o alerta de especialistas para a dificuldade futura de enfrentamento de bactérias, mesmo em infecções simples.
Em alinhamento às ações nacionais e internacionais, os cientistas da Embrapa Suínos e Aves vêm atuando em pesquisas e estudos para o enfrentamento da resistência aos antimicrobianos e auxiliar na execução de políticas públicas. Além de participar de grupos como o da Força-Tarefa do Codex Alimentarius para Resistência Antimicrobiana (FTAMR), que encerrou em 2021.
A Unidade contribui com o Plano de Ação Nacional de Prevenção e Controle da Resistência aos Antimicrobianos no âmbito da agropecuária (PAN-BR Agro) com diversas pesquisas, tais quais o desenvolvimento de insumos biológicos para o controle de bactérias relevantes na avicultura.
Segundo a pesquisadora Clarissa Vaz, líder do projeto que resultou no desenvolvimento do protótipo de biofármaco à base de bacteriófagos, a disponibilidade de um ativo biológico que evita ou reduz o uso de antimicrobianos e seja aplicável ao controle de salmonela na avicultura é desejável frente à importância social e econômica da produção avícola para o País e à necessidade de uso prudente dos antimicrobianos para preservar a eficácia dos que estão disponíveis.
“Esse insumo não pretende substituir o uso terapêutico de antibióticos, mas é uma opção para reforçar o controle de salmoneloses reduzindo o uso desnecessário de antimicrobianos”, explica.
Ainda segundo Vaz, insumos biológicos à base de bacteriófagos não representam necessariamente uma inovação na indústria de saúde e alimentação animal, uma vez que sua ação bactericida é conhecida há muito tempo. “O diferencial é que, se desenvolvidos produtos escalonáveis, de custo acessível, e contendo bacteriófagos adequados, a fagoterapia (uso de bacteriófagos contra infecções bacterianas) é uma possibilidade de diversificar as estratégias de controle de salmonelas aviárias”, pontua.
Foto: Embrapa
Outra vantagem apresentada pela pesquisadora é a de que bacteriófagos nativos são interessantes para o desenvolvimento de produtos voltados ao mercado nacional por não introduzirem cepas exóticas na biodiversidade brasileira e apresentarem maior probabilidade de ação frente às estirpes de campo locais.
Desafio é chegar a produto com potencial de mercado
Os estudos levaram ao desenvolvimento do protótipo de um biofármaco que é fornecido aos frangos pela água de beber, capaz de reduzir o nível de salmonela no intestino de frangos de corte.
“O desafio atual é avançar nas etapas de desenvolvimento até a fase de produção continuada, em condições de colocação no mercado. Esse é um processo que segue a lógica de inovação aberta e repartição de benefícios, por meio do qual a Embrapa e empresas interessadas desenvolvem a pesquisa juntas com o objetivo de desenvolver os seus produtos e aumentar o valor agregado”, observa a pesquisadora.
O produto biológico foi estudado para controle de S. Heidelberg em frangos de corte, com nicho de aplicação contra S. Enteritidis e S. Typhimurium em matrizes, que são algumas das salmoneloses mais impactantes nessas categorias avícolas.
______________







